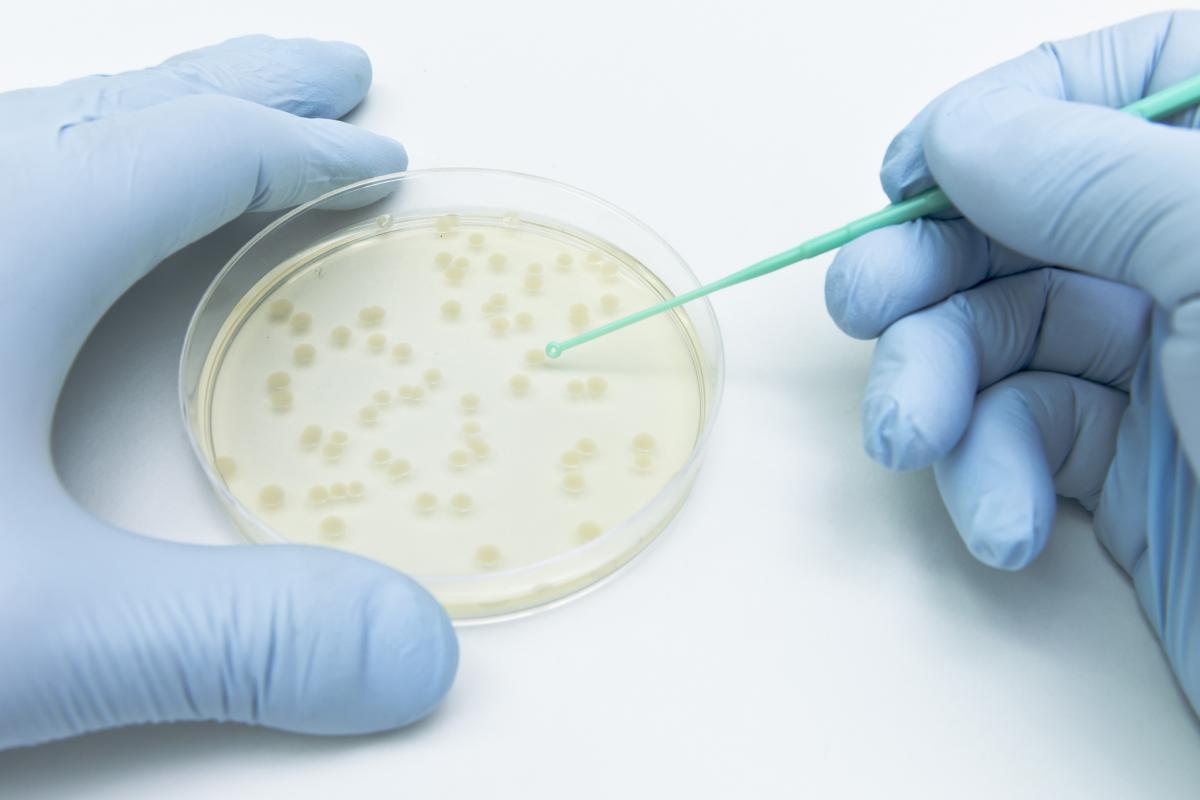

Un antibiótico del pasado siglo puede ser el arma letal contra la superbacterias
Científicos de Harvard han vuelto a estudiarlo.
La resistencia a los antibióticos supone uno de los grandes problemas para la salud del que los expertos llevan tiempo avisando. Científicos de Harvard acaban de publicar un hallazgo que podría arrojar algo de esperanza en este ámbito.
Investigadores del Departamento de Patología del Centro Beth Israel Deaconess, asociado a la mencionada universidad, han hallado que la nourseotricina podría servir contra bacterias ultrarresistentes.
Como explica Infobae, la nourseotricina es "un producto natural fabricado por un hongo del suelo que contiene múltiples formas de una molécula compleja llamada estreptotricina".
Fue descubierta en la década de los 40 y ya en su momento se valoró como agente contra las bacterias Gram negativas, especialmente difíciles de eliminar. Sin embargo, se descubrió que resultaba tóxica para los riñones, por lo que no se ahondó en su estudio.
Ahora, los científicos "caracterizaron la acción antibacteriana, la toxicidad renal y el mecanismo de acción de formas altamente purificadas de dos estreptotricinas diferentes, la D y la F".
La de tipo F, según los investigadores, podría ser menos tóxica a la par que activa contra las bacterias multirresistentes.